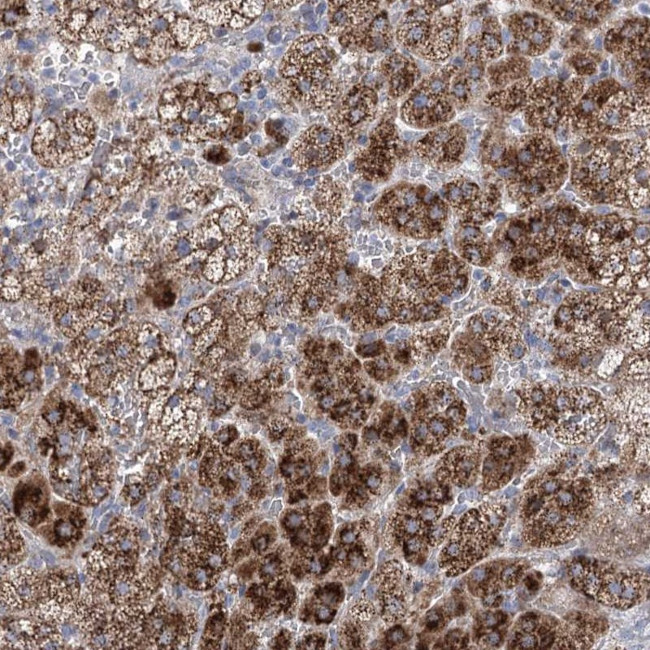
NME7 Antibody in Immunohistochemistry (Paraffin) (IHC (P))

Search
Invitrogen
NME7 Polyclonal Antibody
{{$productOrderCtrl.translations['antibody.pdp.commerceCard.promotion.promotions']}}
{{$productOrderCtrl.translations['antibody.pdp.commerceCard.promotion.viewpromo']}}
{{$productOrderCtrl.translations['antibody.pdp.commerceCard.promotion.promocode']}}: {{promo.promoCode}} {{promo.promoTitle}} {{promo.promoDescription}}. {{$productOrderCtrl.translations['antibody.pdp.commerceCard.promotion.learnmore']}}
产品信息
PA5-58210
种属反应
宿主/亚型
分类
类型
抗原
偶联物
形式
浓度
规格
纯化类型
保存液
内含物
保存条件
运输条件
RRID
产品详细信息
Immunogen sequence: KGVVTEYHDM VTEMYSGPCV AMEIQQNNAT KTFREFCGPA DPEIARHLRP GTLRAIFGKT KIQNAVHCTD LPEDGLLEVQ YFFKI
Highest antigen sequence identity to the following orthologs: Mouse - 89%, Rat - 88%.
靶标信息
Protein kinases are enzymes that transfer a phosphate group from a phosphate donor, generally the g phosphate of ATP, onto an acceptor amino acid in a substrate protein. By this basic mechanism, protein kinases mediate most of the signal transduction in eukaryotic cells, regulating cellular metabolism, transcription, cell cycle progression, cytoskeletal rearrangement and cell movement, apoptosis, and differentiation. With more than 500 gene products, the protein kinase family is one of the largest families of proteins in eukaryotes. The family has been classified in 8 major groups based on sequence comparison of their tyrosine (PTK) or serine/threonine (STK) kinase catalytic domains. The STE group (homologs of yeast Sterile 7, 11, 20 kinases) consists of 50 kinases related to the mitogen-activated protein kinase (MAPK) cascade families (Ste7/MAP2K, Ste11/MAP3K, and Ste20/MAP4K). MAP kinase cascades, consisting of a MAPK and one or more upstream regulatory kinases (MAPKKs) have been best characterized in the yeast pheromone response pathway. Pheromones bind to Ste cell surface receptors and activate yeast MAPK pathway.
仅用于科研。不用于诊断过程。未经明确授权不得转售。
篇参考文献 (0)
生物信息学
蛋白别名: 3'-5' exonuclease NME7; cilia and flagella associated protein 67; NDK7; NDP kinase 7; NDP kinase homolog 7; nm23-H7; non-metastatic cells 7, protein expressed in (nucleoside-diphosphate kinase); Nucleoside diphosphate kinase 7; protein kinase NME7; Putative 3'-5'-DNA exonuclease NDK7; Serine protein kinase NME7; unnamed protein product
基因别名: CFAP67; MN23H7; NDK 7; NDK7; nm23-H7; NME7
UniProt ID: (Human) Q9Y5B8
Entrez Gene ID: (Human) 29922